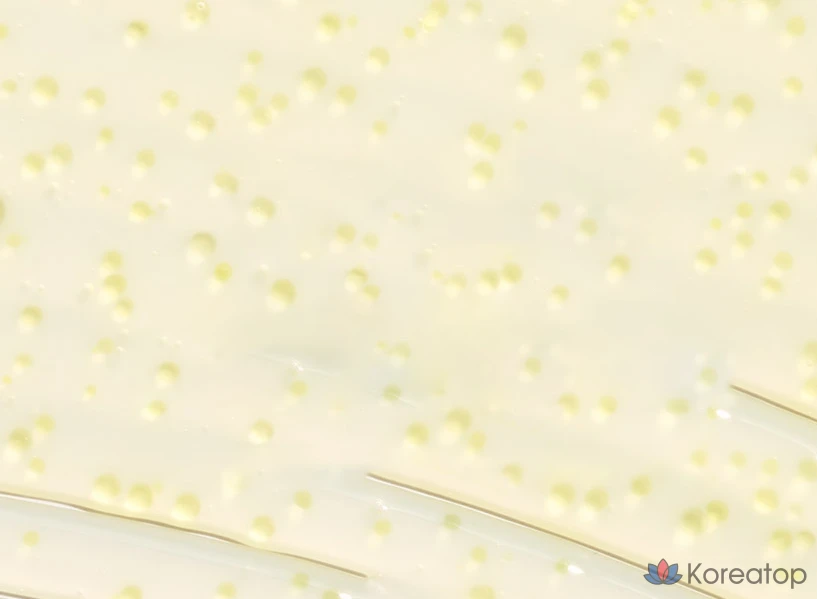
Ампула с низкомолекулярным коллагеном CKD Retino Collagen Low Molecular 300 для внутривенного введения, 30 мл, 1 шт.

Крем CKD Jongkundang Health Retino Collagen Low Molecular 300 Gua Sha Neck Wrinkle Refill, 50 мл, 1 шт.
Вам также может понравиться
Крем для шеи со встроенным массажером-гуаша
Для всех типов кожи, особенно с возрастными изменениями и потерей упругости
Низкомолекулярный гидролизованный коллаген (300 Да), ретиналь (200 ppm), ниацинамид, аденозин, гиалуроновая кислота, гидролизованный эластин, керамиды NP, комплекс аминокислот
Повышение упругости и эластичности, сокращение морщин на шее, лифтинг-эффект, глубокое увлажнение, массажный эффект и улучшение кровообращения
Встречайте инновационный крем для шеи от CKD, который превращает уход в профессиональную процедуру. Уникальность средства — во встроенном массажере-гуаша из стали, который приятно охлаждает кожу, улучшает микроциркуляцию и обеспечивает глубокое проникновение активов. Легкая, нелипкая текстура крема содержит мощный антивозрастной коктейль: низкомолекулярный коллаген (300 Да) и стабильную форму витамина А — ретиналь (200 ppm). Они работают в синергии, чтобы вернуть коже шеи и декольте плотность, разгладить заломы и «кольца Венеры». Просто выдавите крем и массируйте кожу роликом для видимого лифтинг-эффекта и упругости.


















 Telegram
Telegram Вконтакте
Вконтакте Max
Max